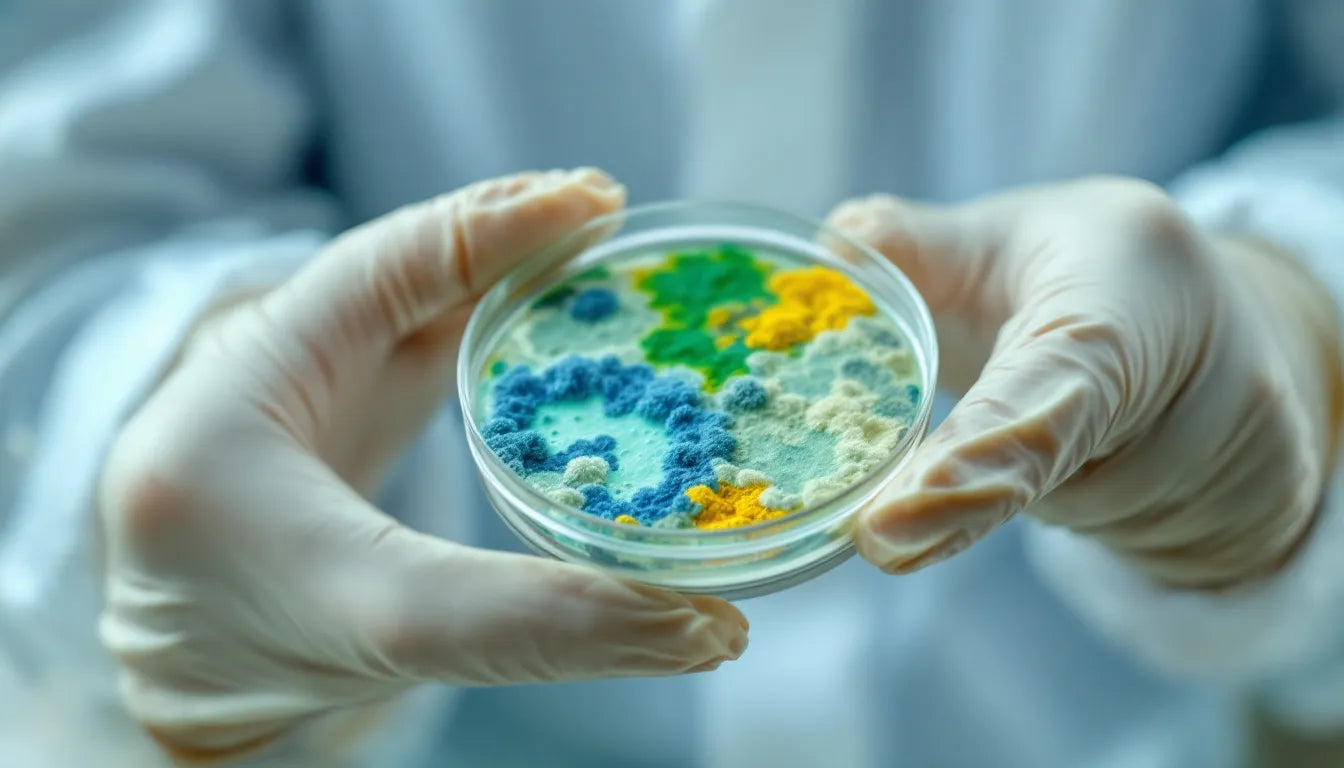

- 🍄 The Snowball strain is a newly developed Psilocybe mushroom with an unconventional, blob-like structure.
- ⚡ Developed by Pope Joseph, this strain grows significantly faster than traditional magic mushrooms.
- 🔬 Genetic modifications allow Snowball to maintain structural consistency across multiple cultivation cycles.
- 🌱 Its unique underground growth pattern resembles truffles, deviating from standard mushroom morphology.
- 🧠 Though potency remains unconfirmed, its lineage from the potent Penis Envy strain suggests strong psychoactive effects.
The discovery of the Snowball strain has sparked intrigue among mycologists and psychedelic enthusiasts alike. Unlike traditional Psilocybe mushrooms, which exhibit a stem, cap, and gills, Snowball grows in dense, cloud-like clusters with an entirely different morphology. Developed by mycologist Pope Joseph through years of genetic experimentation, this strain boasts rapid growth, high yield, and possible psychoactive properties. As psychedelic research and cultivation techniques continue advancing, Snowball may pave the way for novel strains with unique characteristics and potential therapeutic applications. Curious about growing mushrooms yourself? Our grow bags offer a simple, beginner-friendly way to cultivate legal varieties.

The Discovery of the Snowball Strain
The Snowball strain did not emerge naturally—it was the result of deliberate genetic manipulation. Pope Joseph sought to create a mushroom with unique structural features by modifying the well-known Penis Envy strain, one of the most potent magic mushrooms in existence.
Over the course of two years, he experimented with different environmental stressors, substrate compositions, and genetic selection techniques. His efforts led to the identification of a mutation that resisted the normal growth patterns of Psilocybe mushrooms, resulting in the strange, cloud-like morphology of Snowball (Carreón, 2024).
For Joseph, this discovery was a revelation—a proof of concept that genetic manipulation could lead to entirely new mushroom forms. This not only expands the aesthetic and structural diversity of Psilocybe mushrooms but also holds implications for psychedelic cultivation and potential therapeutic applications.

Unique Morphology and Growth Patterns
Snowball is unlike any previously cataloged Psilocybe mushroom. Its lack of a traditional stem, cap, and gills makes it a true anomaly in fungal evolution. Instead, it grows as a dense formation of irregular, rounded clusters, resembling a blob-like mass or a collection of interconnected spheres.
Key Features of Snowball’s Morphology:
- Dense, cloud-like formations instead of typical stem-and-cap structures.
- Extraordinary growth speed, outpacing most other Psilocybe strains.
- Potential underground development, adopting characteristics similar to truffles.
- Resistance to genetic drift, maintaining its unique shape across multiple cloning generations.
This structural deviation raises fascinating questions about the genetic flexibility of Psilocybe mushrooms and whether future strains could be engineered for specific purposes—whether increased potency, structural stability, or ease of cultivation.

Genetic Peculiarities and Rapid Growth
One of Snowball’s most remarkable features is its blistering growth rate. While many mushrooms take weeks to fully mature, Snowball develops significantly faster under optimal conditions. This is a major advantage for cultivators, as it reduces the time required for harvest while potentially increasing consistency in production.
Factors Contributing to Snowball's Growth Efficiency:
- Enhanced genetic stability: Unlike many Psilocybe strains prone to spontaneous mutations, Snowball appears genetically consistent across multiple generations.
- Favorable resistance to environmental factors: Its ability to develop partially underground suggests adaptability to varying humidity and temperature levels.
- High-yield potential: Individual specimens exceeding 1,200 grams in wet weight indicate that Snowball could produce significantly larger harvests compared to traditional strains.
These qualities make Snowball a promising candidate for future large-scale cultivation efforts, especially if researchers can confirm its potency and suitability for therapeutic applications.

Potential Psychoactive Properties
Though official potency analyses have yet to be conducted, Snowball’s genetic lineage strongly suggests high psilocybin levels. Its parent strain, Penis Envy, is renowned for containing up to 50% more psilocybin than standard Cubensis mushrooms, producing particularly intense psychedelic experiences.
Predicted Effects Based on Genetic Lineage:
- Profound introspective states: Likely to facilitate deep self-reflection and enhanced self-awareness.
- Heightened visual distortions: Comparable to other potent Psilocybe mushrooms.
- Strong emotional shifts: Users may experience euphoria, catharsis, or even emotional breakthroughs.
- Potential neuroplasticity benefits: Psilocybin has been studied for its ability to foster new neural connections, which could have implications for mental health treatment.
However, further research, controlled user reports, and official chemical analysis will be required to determine the precise intensity and effects of Snowball.

Mycologists' Take on the Significance of Snowball
Pope Joseph considers the Snowball strain to be an unprecedented milestone in mycological breeding, describing it as proof that unconventional genetic paths can yield completely novel fungal structures.
"We’re entering an era of wild morphology," he states (Carreón, 2024). If mycologists continue experimenting with genetic adaptation, future Psilocybe strains may not only vary in physical appearance but also in chemical composition, offering different psychedelic experiences tailored to personal or clinical needs.
This raises compelling questions about the future of mushroom breeding and whether specific genetic modifications could yield strains designed for targeted applications, such as enhanced therapeutic effectiveness or reduced side effects.

Recreational vs. Therapeutic Use
Pope Joseph does not advocate for Snowball’s use as a party drug or casual psychedelic experience. Instead, he sees all psilocybin mushrooms—including this strain—as tools for personal exploration, healing, and spiritual discovery.
This perspective aligns with the growing acceptance of psychedelic-assisted therapy in clinical settings. As psilocybin decriminalization efforts continue in various parts of the world, new strains like Snowball could one day be researched for their unique contributions to mental health treatment, including:
- Alleviating depression and anxiety
- Facilitating trauma resolution through psychedelic-assisted psychotherapy
- Enhancing mindfulness and meta-awareness
If Snowball proves to have unique psychoactive properties, it could attract interest from researchers studying personalized psychedelic medicine.
The Future of Psychedelic Mycology
Snowball represents just one step in an ongoing revolution in psilocybin mushroom cultivation. As genetic experimentation and selective breeding advance, we may soon see strains that surpass current varieties in terms of potency, therapeutic applicability, and ease of cultivation.
However, legal regulations remain a significant barrier. Many countries still criminalize psilocybin-containing mushrooms, limiting opportunities for scientific study. In regions moving toward legalization or decriminalization, Snowball could play a role in future clinical trials or controlled psychedelic therapy programs.

Cultivation Tips for Mycologists
For those interested in cultivating Snowball, understanding its unique requirements is crucial. Unlike traditional Psilocybe mushrooms, it does not follow typical fruiting body development.
Recommended Cultivation Techniques:
- Maintain consistent humidity levels: As Snowball partially develops underground, ensuring proper moisture content is vital.
- Experiment with nutrient-rich substrates: Its rapid growth may benefit from specially formulated compost blends.
- Monitor genetic stability: Since it retains its shape across multiple generations, tracking genetic deviations could yield useful cultivation insights.
These factors suggest that Snowball could become an attractive choice for both seasoned and amateur cultivators.

Community and Consumer Interest
Early reports indicate excitement within the psychedelic and mycology communities. Online forums and Reddit discussions highlight a mix of fascination and skepticism—some questioning whether such a drastically different structure could impact its psychoactive properties. Others are eager to experiment with Snowball’s cultivation potential, seeing it as a path toward further mushroom innovation.
Ethical considerations also emerge as researchers and cultivators push the boundaries of genetic modification. Questions about intentionally breeding high-potency strains for recreational purposes versus prioritizing medical research will shape the future of psychedelic cultivation.
The Snowball strain stands as a testament to the rapidly evolving field of psychedelic mushroom genetics. Its unique structural properties, rapid growth, and potential psychoactive effects make it a subject of intrigue within the broader world of psilocybin research. As legal, scientific, and ethical discussions around psychedelics continue progressing, Snowball may represent an early step toward a future where Psilocybe mushrooms are deliberately cultivated to serve therapeutic and medicinal needs.
FAQs
What is the Snowball strain of Psilocybe mushrooms?
Snowball is a newly discovered Psilocybe mushroom strain that grows in dense, cloud-like clusters rather than the traditional stem-and-cap structure.
How was it discovered and developed?
It was developed by mycologist Pope Joseph after two years of genetic experimentation aimed at modifying the Penis Envy mushroom.
What makes Snowball different from other magic mushrooms?
Its unique morphology—lacking a stem, cap, and gills—along with its rapid growth and underground development set it apart.
How does it grow, and what are its unique characteristics?
Snowball grows faster than most Psilocybe mushrooms, retains its genetic structure across multiple cloning attempts, and can reach exceptional sizes.
What are the potential psychoactive effects?
While not officially confirmed, its genetic lineage suggests strong psychedelic effects potentially enhancing introspection and self-awareness.
How does this strain contribute to psychedelic research and culture?
Its genetic stability and rapid growth could make it a valuable subject for studying psilocybin mushrooms' therapeutic potential.
Does it offer benefits in therapeutic or spiritual contexts?
Yes, its creator believes that psilocybin mushrooms, including Snowball, can deepen self-discovery and spiritual understanding.
What does the emergence of strains like Snowball signal for the future of mycology?
It suggests a growing era of genetic experimentation and innovation, potentially leading to specialized strains for medical and personal use.
Citations
Carreón, M. (2024). There’s a New Magic Mushroom on the Market Called Snowball. The Drop In.



